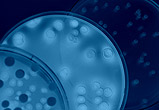

Luftreiniger gegen Schadstoffe
Aktuelles Thema
Gesunde Luft- und Lebensbedingungen in unserem Lebens- und Wohnraum haben
eine große Bedeutung für unsere Gesundheit und das Wohlbefinden.
Die steigende Belastung durch Schadstoffe biologischer oder chemischer Herkunft
ist immer mehr zum aktuellen Thema in unserer Gesellschaft geworden. Um
Schadstoffe in Innenräumen besser in den Griff zu bekommen, werden
nicht nur in Deutschland vom Bundesumweltamt, sondern auch von der Europäischen
Union und dem europäischen Regionalbüro der Weltgesundheitsorganisation
WHO große Anstrengungen unternommen.
"Dicke Luft"?
Zum Wohlfühlen gehört saubere, frische Atemluft. Aufgrund der
zunehmenden Belastung durch Feinstaub und Schadstoffe ist saubere Luft aber
leider keine Selbstverständlichkeit mehr. Viele Stoffe, die beispielsweise
beim Heizen und Kochen entstehen, können gesundheitliche Beeinträchtigungen
auslösen. Viel häufiger jedoch sind Schadstoffe aus Baustoffen,
Teppichen, Möbeln, Haushaltschemikalien und dem bekannten Problem Tabakrauch.
Auch die Luft aus unserer Wohngegend spielt eine größere Rolle
durch die Luft, die beim Lüften in unseren Wohnraum gelangt. An verkehrsreichen
Straßen und besonders in Ballungsräumen nimmt die Luftqualität
rapide ab. Gute und effektive Luftreiniger können die Raumluft von
Geruchs- und Staubpartikel befreien.
Schadstoffe in der Raumluft
|

|
 |
 |
| Keime, Sporen Milbenallergene |
Schädliche Abgase, Feinstaub |
Tabakrauch (stark vergrößert) |
VOC, Gase Flüchtige Stoffe |
Was sind VOC oder flüchtige, organische Stoffe?
Das sind Luftschadstoffe, die inzwischen in jeder Wohnung zu finden sind.
Die Abkürzung VOC steht für "Volatile Organic Compounds"
und kommt wie sovieles aus der englischen Sprache. Dabei handelt es sich
um eine Vielzahl natürlicher, aber auch synthetischer Stoffe, die schon
bei normaler Raumtemperatur aus Innenraumaterialien ausgasen. Die Ausdünstung
kommt aus Dingen des täglichen Bedarfs, der Innenaustattung, Teppichen,
Textilien, Farben und Möbeln. Oft sind sie in aromatischen Kohlenwasserstoffen,
Haushaltschemikalien, Lacken, Klebstoffen, Lösemitteln, Fettlösern
und Druckerzeugnissen nachweisbar. Luftreiniger mit Aktivkohlefiltern können
die gasförmigen Schadstoffe aufnehmen und im Filtersystem neutralisieren.
Schadstoffe kleben an Staub und Oberlächen
Selbst schwerflüchtige Stoffe gasen nach einiger Zeit aus, haften an
Oberflächen und reichern sich im Hausstaub an. Mit neuen Materialien
und Produkten wird das Spektrum für Schadstoffe permanent erweitert.
Ob damit ein gesundheitliches Risiko verbunden ist, lässt sich meist
nicht
so einfach feststellen. Geeignete Luftreiniger können in den meisten
Fällen zumindest eine Linderung der Symptome bewirken.
Gesundheitliche Risiken
Bekannte Reizstoffe sind beispielsweise Formaldehyd, Kohlendioxid, Ammoniak
und Chlorid. Viele Materialien riechen schon in niedrigen Konzentrationen.
Bei höherer Konzentration treten Reizungen der Augenbindehaut, der
Schleimhäute und der Atemwege auf. Auch verstärkt auftretende
Müdigkeit, Schwindelgefühl und Kopfschmerzen sind bekannte Symptome.
Hervorgerufen werden können diese Probleme gleichermaßen durch
natürliche und synthetische Stoffe.
Was ist MCS?
Viele Menschen fühlen sich der Vielzahl der Fremdstoffe in den eigenen
vier Wänden hilflos ausgesetzt und führen ihre gesundheitliche
Probleme auf diese Situation zurück. Man spricht dann von MCS ( Multiple
Chemical Sensitivity ). Dies entspricht dem Krankheitsbild der Überempfindlichkeit
gegen Chemikalien. MCS hat in den letzten Jahren bereits erschreckende Ausmaße
angenommen und wird kontrovers diskutiert.
Feinstaub, Hausstaub
Bei älteren Menschen und Patienten mit Atemwegs- und Herz- Kreislauferkrankungen
können Schadstoffe zu einer Zunahme der Beschwerden und sogar einer
verringerten Lebenserwartung führen. Feinstaub nimmt Schadstoffe auf
und bindet diese in den Partikeln. Hausstaub besteht aus feinen Partikeln,
die sowohl aus der Außenluft der Wohnung eingetragen werden oder aber
direkt aus der Wohnung stammen. Die Teilchen stammen aus dem Abrieb von
natürlichen und künstlichen Fasern, Haaren, Hautschuppen, Schimmelsporen
und Verbrennungsrückständen. Im Hausstaub werden somit meist unerwünschte
Bestandteile nachgewiesen. Dazu gehören Schwermetalle, Pilzsporen,
Pollen, Ausscheidungen von Hausstaubmilben, Schädlingsbekämpfungsmittel
und flüchtige organische Verbindungen. Die gesundheitsschädigende
Wirkung durch den Hausstaub wird durch die Kombination der enthaltenen Schadstoffe
zusätzlich verstärkt.
Einsatzmöglichkeiten Hepa Luftreiniger
Je nach Einsatzfall, Belastung durch Schastoffe und die jeweilige Raumgröße
können geeignete Luftreiniger aufgestellt werden. Beispiele für
die Luftreinigung sind Büro, Arbeitsplatz, Wohnraum, Schlafraum, Raucherraum,
Aufenthaltsraum, Gastronomie, Hotel, sowie der medizinische Bereich Krankenhaus,
Arztpraxis und Klinik.
Mehr Informationen:
![]() Hepafilter
Hepafilter
![]() Luftreiniger Funktion
Luftreiniger Funktion



